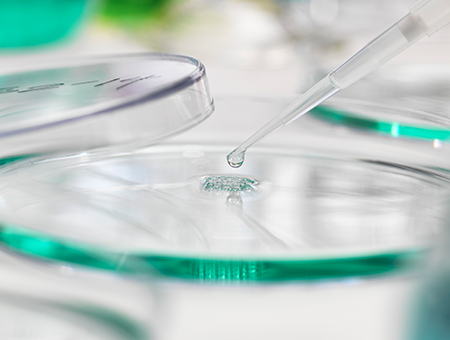

Definition
NK Cell Therapy
엔케이셀 치료

인체의 선천 면역을 담당하는 NK세포는 나이가 들수록 감소합니다.
체내 NK세포 활성도를 증가시켜 바이러스, 박테리아, 암세포로부터
우리 몸을 스스로 지킬 수 있도록 합니다.
-
 항노화 효과
항노화 효과
-
 면역기능 향상
면역기능 향상
-
 만성피로 회복
만성피로 회복
-
 내장 기능 개선
내장 기능 개선